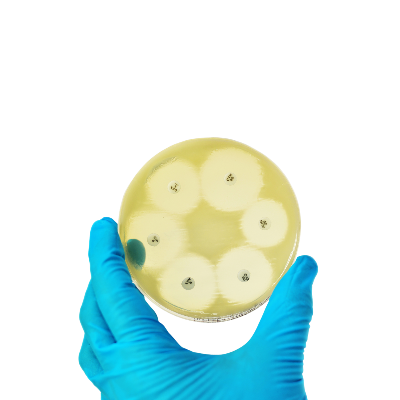

Cookies; We use it to ensure that our site functions properly, to personalize content and advertisements, to provide social media features, and to analyze our site traffic. At the same time, information about your use of the site; We share it with our social media, advertising and analytics partners.
Accept All Cookies
Cookies used for the stable operation of the BulutKlinik website.
| Cookie Name |
Purpose |
Time |
| privacy_policy_accept |
We keep the information regarding your acceptance of the cookie policy. |
1 Year |
| allowed_cookies |
We keep the information regarding which cookies you accept. |
1 Year |
| XSRF-TOKEN |
Allows your visitor identity to be automatically verified in the background |
2 Hours |
| bulutklinik_session |
Used for the site to recognize you |
2 Hours |
Analytical cookies are used to understand how visitors interact with the website. These cookies include visitor count, bounce rate, traffic source, etc. It helps to provide information about measurements such as
We may collect information about your online activities on our sites to serve ads about products and services tailored to your individual interests. For this purpose, we may also obtain information from third-party websites where our advertisements are served.